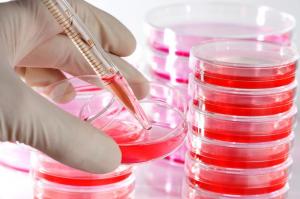

Cell and Tissue Culture Supplies Market Research Provides an In-Depth Analysis on the Future Growth Prospects till 2028
A cell culture is basically keeping the cells taken out of a source in an artificial environment alive.
SEATTLE, WASHINGTON, UNITED STATES, April 7, 2022 /EINPresswire.com/ -- The Global Cell and Tissue Culture Supplies Market exclusive insights, Opportunities and revenue size estimation, and growth factors. Cell and Tissue Culture Supplies Market report aims to deliver an opportunity for companies to recognize the modern trends, market size, growth, share, segments, manufacturers, and technologies, future road map, and 2028 forecast. The Study is segmented by major and emerging countries having high potential and elaborates qualitative and quantitative information including market size breakdown by revenue and volume (if applicable).
The research focuses on the drivers and restraints that impact market dynamics in the current context. A SWOT analysis of companies, all current advancements, future launches, joint ventures, mergers, and accusations of industry-relevant firms are all evaluated in order to arrive at market size prediction and growth estimation.
Get Sample Report Here with (Including Full TOC, Table & Figures) @ https://www.coherentmarketinsights.com/insight/request-sample/3770
𝐂𝐨𝐦𝐩𝐞𝐭𝐢𝐭𝐢𝐯𝐞 𝐋𝐚𝐧𝐝𝐬𝐜𝐚𝐩𝐞: Becton, Dickinson and Company, Merck KGaA, Corning, Inc., Lonza Group, Eppendorf AG, Thermo Fisher Scientific, Inc., Affymetrix, Inc., GE Healthcare, VWR International, LLC, and WHEATON Industries, Inc.
Cell and Tissue Culture Supplies Market Share Analysis:
The Cell and Tissue Culture Supplies Market Share Analysis examines suppliers in terms of their contribution to the market as a whole. It gives a sense of how much income it generates in comparison to other suppliers in the sector. It gives information on how suppliers compare to one another in terms of revenue creation and client base. For the base year, knowing market share gives you an indication of the size and competitiveness of the suppliers. It reflects the market's accumulation, fragmentation, dominance, and amalgamation features.
Furthermore, the study assists users in identifying growth determinants as well as new entrant prospects in the Cell and Tissue Culture Supplies Market sector. The research report contains a thorough examination of the Cell and Tissue Culture Supplies Market's potential, technical advancements, and trends. The research covers all of the market's main suppliers as well as small businesses who are looking to extend their operations on a global basis. Using historical data, the research gives strategic analyses and proposals for future entrants.
Cell and Tissue Culture Supplies Market Segmentation:
Cell and Tissue Culture Supplies Market, By Product Type:
✅Consumables Products
✅Media
✅Classical Media
✅Lysogeny Broth
✅Chemically Defined Media
✅Specialty Media
✅Serum Free Media
✅Protein Free Media
✅Reagents
✅Growth Factors & Cytokines
✅Albumin
✅Amino Acids
✅Thrombin
✅Protease Inhibitors
✅Others
✅Sera
✅Fetal Bovine Serum
✅Others
✅Contamination Detection Kits
✅Cryoprotective Agents
✅Instruments
✅Culture Systems
✅Biosafety Cabinets
✅Incubators
✅Cryostorage Equipment’s
✅Roller Bottle Equipment’s
✅Pipetting Instruments
✅Others
Cell and Tissue Culture Supplies Market, By Application:
✅Biopharmaceutical Production
✅Vaccine Production
✅Drug Screening & Development
✅Gene Therapy
✅Toxicity Testing
✅Cancer Research
✅Others
The regional analysis covers:
North America (U.S. and Canada)
Latin America (Mexico, Brazil, Peru, Chile, and others)
Western Europe (Germany, U.K., France, Spain, Italy, Nordic countries, Belgium, Netherlands, and Luxembourg)
Eastern Europe (Poland and Russia)
Asia Pacific (China, India, Japan, ASEAN, Australia, and New Zealand)
The Middle East and Africa (GCC, Southern Africa, and North Africa)
PDF Brochure Of This Report @ https://www.coherentmarketinsights.com/insight/request-pdf/3770
The Report’s Importance:
♦ To provide a thorough examination of the market structure, as well as predictions for the major segments and sub-segments of the global Cell and Tissue Culture Supplies market during the forecast period.
♦ To provide information on the factors that influence market growth.
♦ To conduct an initial analysis of the global Cell and Tissue Culture Supplies market utilizing various techniques, including Supplier Evaluation and Porter’s Five Forces Analysis.
♦ Provide historical and projected revenue for market segments and sub-segments based on regions and key countries.
♦ To provide country-specific market analysis in terms of current market size and prospects.
Key questions answered in the report:
• Who are the global key players in this Cell and Tissue Culture Supplies market?
• What’s their company profile, product information, contact information?
• What was the global market status of the market?
• What was the capacity, production value, cost, and profit of the market?
• What are projections of the global industry considering capacity, production, and production value?
• What will be the estimation of cost and profit?
• What will be market share, supply, and consumption?
• What is market chain analysis by upstream raw materials and downstream industry?
• What are the market dynamics of the market?
Buy This Cpmplete Business Report with Flat USD 2000 Off @ https://www.coherentmarketinsights.com/promo/buynow/3770
Reasons to Buy this Cell and Tissue Culture Supplies Market Report
➡ Save time carrying out entry-level research by identifying the size, growth, and leading players in the emerging Cell and Tissue Culture Supplies market
➡Use the Five Forces analysis to determine the competitive intensity and therefore attractiveness of the emerging Cell and Tissue Culture Supplies market
➡Leading company profiles reveal details of key Cell and Tissue Culture Supplies market players emerging five operations and financial performance
➡Add weight to presentations and pitches by understanding the future growth prospects of the emerging Cell and Tissue Culture Supplies market with five year historical forecasts
➡Compares data from North America, South America, Asia Pacific Europe and Middle East Africa, alongside individual chapters on each region .
About Us:
Coherent Market Insights is a global market intelligence and consulting organization that provides syndicated research reports, customized research reports, and consulting services. We are known for our actionable insights and authentic reports in various domains including aerospace and defense, agriculture, food and beverages, automotive, chemicals and materials, and virtually all domains and an exhaustive list of sub-domains under the sun. We create value for clients through our highly reliable and accurate reports. We are also committed in playing a leading role in offering insights in various sectors post-COVID-19 and continue to deliver measurable, sustainable results for our clients.
Mr. Shah
Coherent Market Insights Pvt. Ltd.
+1 206-701-6702
email us here
Visit us on social media:
Facebook
Twitter
LinkedIn
Other
Legal Disclaimer:
EIN Presswire provides this news content "as is" without warranty of any kind. We do not accept any responsibility or liability for the accuracy, content, images, videos, licenses, completeness, legality, or reliability of the information contained in this article. If you have any complaints or copyright issues related to this article, kindly contact the author above.